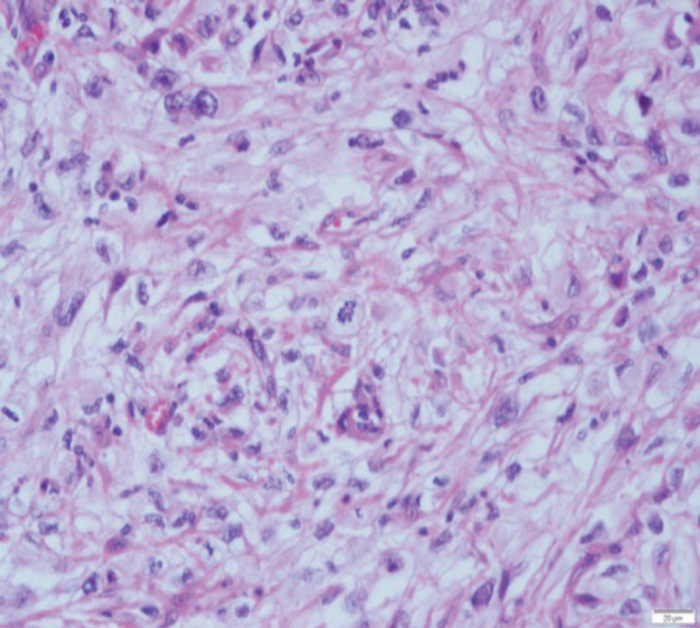
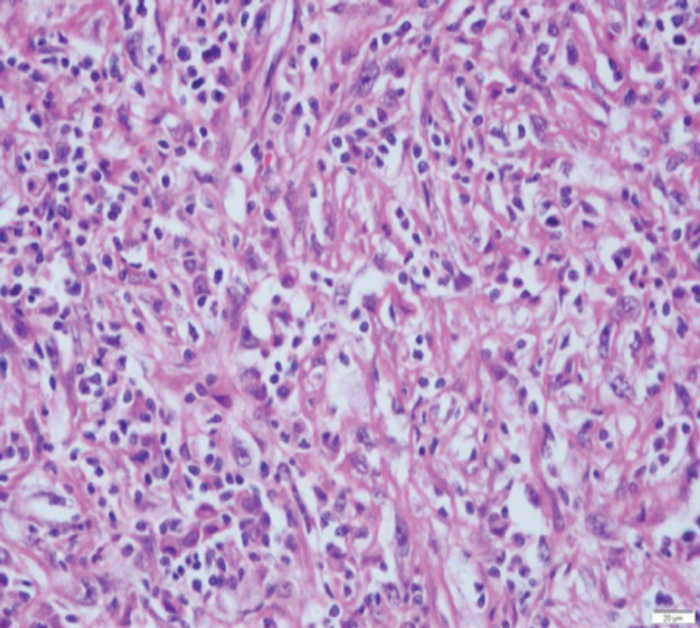

Renal cell carcinoma (RCC) represents 2-3% of all cancers [1]. It is an adenocarcinoma making up 85% of all renal malignancies. Sarcomatoid transformation is a microscopically identified feature of RCC accounting for 5% of all RCCs [2]. Known as sarcomatoid renal cell carcinoma (sRCC) it is not a recognised subtype of RCC because sarcomatoid features can be found in all subtypes of RCC. Although rarely seen, it is an aggressive feature that tends to present at an advanced stage in the disease process accounting for 15-20% of patients with advanced disease [2].
Survival is poor for this group of patients and systemic treatments are often not durable. It is an indicator of poor outcome; therefore, it is important to be aware of this highly aggressive entity when managing patients with RCC. We present a synopsis of the literature concerning the pathology and management of sRCC.
Incidence
The incidence and mortality of RCC has been rising. Over the last two decades the incidence of RCC has increased by about 2% both in Europe and worldwide [3]. In 2012 there were approximately 84,400 new cases of RCC and 34,700 kidney-cancer-related deaths in the European Union. In the United Kingdom 8228 patients were diagnosed in 2008, an increase from 3676 patients in 1999. There is also an increase in mortality in the UK with 3848 deaths in 2008 [4]. sRCC accounts for 5% of these cancers with almost 20% at tumour stage 4 [2].
Aetiology
RCC is 1.5 times more common in males than in females with a peak incidence between 60-70 years of age [4].
Environmental risk factors include smoking, obesity, hypertension, renal failure / dialysis, occupational asbestos and cadmium exposure.
Genetic risk factors include von hippel-Lindau (VHL) syndrome, hereditary papillary RCC, Birt-Hogg-Dube syndrome, hereditary leiomyomatosis and having a first degree relative with RCC. Anatomical risk factors for RCC include horseshoe kidney and polycystic kidney disease.
Pathology
The main subtypes of RCC include clear cell, papillary (Type 1 and 2) and chromophobe renal cell cancer. Other less common subtypes include carcinoma of the collecting ducts of Bellini, renal medullary carcinoma and acquired cystic disease-associated RCC.
Pathological features which will determine the aggressiveness of the tumour include grade, stage, sarcomatoid features, vascular invasion, necrosis, invasion of collecting ducts and into peri-renal fat.
sRCC represents a form of high grade transformation, rather than a distinct subtype of RCC [5]. Cells with sarcomatoid features are thought to represent primary RCC tumour cells that have undergone dedifferentiation. Tumour protein 53 has been implicated in this process [12].

Figure 1: sRCC macroscopic specimen.

Figure 2: (A) sRCC tumour. (B) sRCC metastases to lymph node.
sRCC macroscopically, has a solid white appearance [Figure 1]. Microscopically, it contains spindle-like cells, cellular atypia and high cellularity which are features found in sarcomas [Figure 2]. They do not contain epithelial components and they can be uniform or heterogeneous. The majority will contain some carcinoma elements, while 90% will have tumour necrosis and 30% will have lymphovascular invasion. More than 80% of sRCC are found in clear cell carcinoma [10]. sRCC tends to be associated with high grade tumours however, more than 30% can also be found in low grade tumours [11]. Due to its aggressive nature and poor prognosis it is often looked at as independent prognostic factor when managing RCC.
Importantly, primary sarcomas differ from sRCC features in the following ways: they should not contain any areas of RCC, over half of them contain smooth muscle (leiomyosarcomas) and primary sarcomas are extremely rare in adults [13].
Diagnosis
Renal carcinoma presents with the classic triad of symptoms including loin pain, haematuria and a mass in about 6-10% of cases. However, about 50% are diagnosed incidentally on imaging [4]. Thirty percent of patients will present with symptoms of metastatic disease and associated systemic symptoms. Less common features include varicocoele, and lower limb oedema. Paraneoplastic syndromes are present in about 30% of cases [4].
sRCC tends to present at a much more advanced stage than other RCCs. Ninety percent will be symptomatic at presentation with 45-84% having metastatic disease at similar sites to other RCCs [6]. sRCC tends to be very large at presentation with a mean size of 9-10cm.
Investigations
The investigations performed for sRCC should be the same as for any other RCC including blood tests to assess full blood count and renal function, imaging and histological diagnosis when appropriate. Imaging methods include ultrasonography (USS), computed tomography (CT) and magnetic resonance imaging (MRI). In CT imaging the renal mass is characterised by the features before and after administration of intravenous contrast. Enhancement of the mass measured in Hounsfield units of 15 or more is considered to have a high likelihood of malignancy [7]. CT and MRI give information about tumour extension, venous involvement, lymphadenopathy, involvement of the adrenals / surrounding structures and the state of the contralateral kidney. These imaging studies however cannot distinguish between the different histological subtypes or high-risk features [Figure 3].

Figure 3: CT scan showing a left RCC in coronal section but there are no
specific radiological features to differentiate conventional RCC from sRCC.
Core tumour biopsy can sometimes play a role in the diagnosis of RCC but, its role in identifying sRCC is less studied. The amount of tissue obtained from core biopsies can be insufficient to diagnose RCC in large tumours and often there is less than 50% of sarcomatoid features in these tumours leading to sampling errors. Their heterogenous nature means that it can be difficult to obtain adequate biopsies. About 10% of patients who have nephrectomy for sRCC have sRCC features in the pre-nephrectomy biopsies [8]. Resection of distant metastases can sometimes be used to establish a diagnosis however, more than 30% of distant lesions from sRCC do not contain sarcomatoid changes therefore, it is not a reliable method (sensitivity 10%) [9].
Therefore, there is no reliable method to identify sRCC preoperatively.
Management
Surgery
sRCC is often treated surgically as conventional RCC because there is no reliable test to identify sRCC preoperatively and the diagnosis of sRCC is often made based upon the surgical specimen pathology after radical surgery.
sRCC tends to be more aggressive in nature, therefore at presentation they are usually larger in size and / or have metastatic disease. Very occasionally it presents in the early stages, but due to the nature of sRCC tends to be more vascular, and with desmoplastic changes that adhere to the adjacent structures, making nephron-sparing surgery difficult. Therefore, radical total nephrectomy is often the standard treatment.
Retroperitoneal lymph node dissection in the setting of renal cancer is controversial as the lymph node drainage pattern of the kidney is variable and the template of lymph node dissection has yet to be defined. However, in the setting of locally advanced disease and / or unfavourable clinical / pathological features such as sRCC, an extended lymph node dissection has been recommended in some retrospective studies [16]. The nodal dissection result may provide additional prognostic indication, but the therapeutic benefit remains questionable as many of the node-positive patients often have established distant metastatic disease at the outset.
Cytoreductive nephrectomy is often performed in sRCC, because of the lack of reliable clinical tests to diagnose sRCC preoperatively. In the rare occasions where sRCC is diagnosed preoperatively (e.g. by needle biopsy) and in the presence of metastases, some authors suggest cytoreductive surgery is not advisable due to the rapid progression associated with the disease during convalescence post-surgery, meaning that most patients do not receive adjuvant systemic therapy [5].
Alternative treatment such as minimally invasive procedures with cryotherapy or radio-frequency ablation remain unproven in these aggressive tumours.
Systemic treatment
sRCC is a rare entity and consequently appropriate systemic treatment is largely undefined. It appears that sRCC has a less desirable response to systemic therapy compared to non-sRCC. Some authors suggest that immunotherapy has produced less favourable results than chemotherapy and anti-angiogenesis targeted therapy. Traditional sarcomas are treated with chemotherapy and so this instigated its use in sRCC. Gemcitabine and doxorubicin are the choices for chemotherapy in sRCC which have shown some durable response [17]. Median progression free survival and overall survival were shown to be 3.5 and 8.8 months respectively [18]. Tyrosine kinase inhibitors have been used in the treatment of sRCC showing more promising results. The median progression free survival and overall survival were better than in chemotherapy, 5.3 and 11.8 months respectively [19].
Prognosis
Prognostic factors in RCC can be classified as anatomical, histological and clinical [Table 1]. The prognosis associated with sRCC is worse than for non-sRCC tumours in both early stage and advanced stage disease. Survival time after diagnosis for sRCC is only four to nine months [5]. One study found that in all patients with grade 4 tumours (M0 and M1) with the presence of sarcomatoid change there is a 58% increased risk of cancer-specific death related to RCC (p<0.001) and in those without metastases (M0) with sarcomatoid change there was an 82% increased risk of death related to RCC (p<0.001) [14]. The percentage of sarcomatoid features within RCC has been found to be a poor prognostic factor and to increase the risk of death from RCC [14,15]. The one to two year survival rates for patients undergoing radical nephrectomy with localised sRCC are similar to those patients undergoing cytoreductive nephrectomy for non-sRCC [2] therefore, patients with sRCC are likely to need adjuvant systemic therapy after nephrectomy.
Follow-up
Surveillance after radical treatment for RCC should be based upon risk stratification. [Ed comment: could the authors please add the criteria used for risk stratification into low, intermediate and high risk?]
There is no agreed consensus as to which protocol should be followed or the length of duration of follow-up however, many have been proposed. These patients should be stratified into categories that predict the risk of metastases (low, intermediate or high risk) and followed up with CT of the thorax, abdomen and pelvis at regular intervals. A common method used is the Mayo Clinic scoring system which gives an accumulated risk of metastases following nephrectomy for clear cell RCC [20]. The European Association of Urology guidelines on RCC recommend regular follow-up with imaging based on the risk stratification [Table 2].
Conclusion
sRCC is an aggressive feature found in all subtypes of RCC which is associated with disease progression and poor prognosis. Aggressive treatment strategies and close surveillance are required when dealing with sRCC as well as the awareness of its high-risk features when evaluating patients in the multidisciplinary team meetings.
References
1. European Network of Cancer Registries: Eurocim version 4.0. 2001: Lyon, France.
2. Cheville JC, Lohse CM, Zincke H, et al. Sarcomatoid renal cell carcinoma: An examination of underlying histologic subtype and an analysis of associations with patient outcome. Am J Surg Pathol 2004;28:435-441.
3. Lindblad P. Epidemiology of renal cell carcinoma. Scand J Surg 2004;93:88.
4. Reynard J, Brewster S, Biers Suzanne. Oxford Handbook of Urology, third edition. 2013; 27:279.
5. Shuch B, Bratslavsky G, Linehan W, Srinivasan R. Sarcomatoid renal cell carcinoma: A comprehensive review of the biology and current treatment strategies. The Oncologist 2012;17:46-54.
6. Mian BM, Bhadkamkar N, Slaton JW et al. Prognostic factors and survival of patients with sarcomatoid renal cell carcinoma. J Urol 2002;167:65-70.
7. Israel GM et al. Pitfalls in renal mass evaluation and how to avoid them. Radiographics 2008;28:1325.
8. Abel E, Culp S, Margulis V et al. Use of percutaneous primary tumor biopsy to predict high risk pathologic features in patients with metastatic renal cell carcinoma [abstract 311]. Presented at the 2009 American Society of Clinical Oncology Genitourinary Cancer Symposium, Orlando, Florida, February 26-28, 2009.
9. Shuch B, Said J, LaRochelle JC et al. Histologic evaluation of metastases in renal cell carcinoma with sarcomatoid transformation and its implications for systemic therapy. Cancer 2010;116:616-624.
10. de Peralta-Venturina M, Moch H, Amin M et al. Sarcomatoid differentiation in renal cell carcinoma: A study of 101 cases. Am J Surg Pathol 2001;25:275-284.
11. Ro JY, Ayala AG, Sella A et al. Sarcomatoid renal cell carcinoma: Clinicopathologic. A study of 42 cases. Cancer 1987;59:516-526.
12. Shush B et al. Understanding pathologic variants of renal cell carcinoma: Distilling therapeutic opportunities from biologic complexity. European Urology 2015;67:85-97.
13. Vogelzang NJ, Fremgen AM, Guinan PD et al. Primary renal sarcoma in adults. A natural history and management study by the American Cancer Society, Illinois Division. Cancer 1993;71:804-10.
14. Zhang BY, Thompson RH, Lohse CM et al. A novel prognostic model for patients with sarcomatoid renal cell carcinoma. BJU Int 2015;115:405-11.
15. Shuch B, Bratslavsky G, Shih J et al. Impact of pathological tumour characteristics in patients with sarcomatoid renal cell carcinoma. BJU Int 2012;109:1600-6.
16. Blute ML, Leibovich BC, Cheville JC et al. A protocol for performing extended lymph node dissection using primary tumor pathological features for patients treated with radical nephrectomy for clear cell renal cell carcinoma. J Urol 2004;172:465-9.
17. Nanus DM, Garino A, Milowsky MI et al. Active chemotherapy for sarcomatoid and rapidly progressing renal cell carcinoma. Cancer 2004;101:1545-51.
18. Haas N, Manola J, Pins M et al. ECOG 8802: Phase II trial of doxorubicin (Dox) and gemcitabine (Gem) in metastatic renal cell carcinoma (RCC) with sarcomatoid features [abstract 285]. Presented at the 2009 American Society of Clinical Oncology Genitourinary Cancer Symposium, Orlando, Florida, February 26-28, 2009.
19. Sella A, Logothetis CJ, Ro JY et al. Sarcomatoid renal cell carcinoma. A treatable entity. Cancer 1987;60:1313-8. 20. Leibovich BC, et al. Prediction of progression after radical nephrectomy for patients with clear cell renal cell carcinoma: a stratification tool for prospective clinical trials. Cancer 2003;97:1663.





